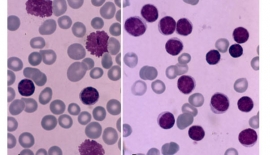
Akut Lenfositik Lösemi

Yenilenen Web Sitemizi nasıl buldunuz?
- Sağlık Kataloğu,İletişim

Yenilenen Web Sitemizi nasıl buldunuz?

Sosyal medyada bizi takip edin!

Tüm Nöbetçi Eczanelere Tek noktadan göz atın.

Obeziteyle Mücadele Hareketi

Annem 86 yaşında, 30 yıldır hipertansiyonu var. Gelişen depresyon nedeniyle psikiyatrist Reserpin isimli ilacı kesmemizi önerdi. Ne yapmalıyız? A.T./İstanbul Reserpin, 50-60 yıllık eski bir tansiyon.....
Haberin Devamı
Burnun en önemli görevlerinden biri solunumdur. Eğer bu görev tam anlamıyla yapılamıyorsa burun tıkanıklığından bahsedilir. Burun boşluğu ortada septum adı verilen ve kıkırdak ile kemikten yapılı bir bölme ile ikiye ayrılır. Her iki tarafta da konka adı verilen etler bulunur. Bu etler solunum havasının nemlendirilmesi ve ı...
Devamı
Kabakgillerden elma iriliğinde meyvesi çok acı ve ishal yapıcı bir bitkidir. İçeriğinde "colocynthine" vardır. Zehirlidir. 2 gramdan fazlası öldürebilir. Haricen kullanılır. Kullanıl...
Devamı
Baklagillerden tırmanıcı bir bitki ve onun tohumudur. Faydası: Kabızlığı giderir. Kan yapar. Kan kanserine karşı korur....
Devamı
Turpgiller familyasından; dik saplı, küçük beyaz çiçekli bir bitkidir. Oluşturulduğu zaman sarımsak kokusu verir. Hemen hemen her yerde bulunur. Kullanıldığı yerler: Temriye uyuz ve ...
Devamı
Çiçeksiz bitkilerin; suların yüzünde veya diplerinde bulunan bir şubesidir. Kullanıldığı yerler: Sürüldüğü yerleri zayıflatır. Haşlanması bağırsak kurtlarını döker. Saçlar...
Devamı
Nergisgiller familyasından; soğanı zehirli bir bitkidir. Baharda çiçekleri ilk açan bitkilerdendir. Çiçeği, çıplak bir sapın ucunda biraz eğik durur. Birçok türü vardır. Kullanıld...
Devamı
Ballıbabagiller familyasından; Haziran - Eylül ayları arasında pembe ve seyrek olarak da beyaz renkli çiçekler açan, otsu bir bitkidir. 10 - 30 cm boyundadır. Yaprakları; karşılıklı, tü...
Devamı
Turpgiller familyasından; akarsu kenarlarında yetişen çok yıllık otsu bir bitkidir. Gövdesi yeşil renkli, köşeli, parlak ve yatıktır. Boyu 30-40 cm kadardır. Kökü çoktur. Çiçekleri b...
Devamı
Turpgiller familyasından; beyaz veya mor çiçekli otsu bir bitkidir. Birçok türü vardır. Kullanıldığı yerler: Basur memelerini tedavi eder. Boğaz ağrılarını geçirir....
Devamı
Karanfilgiller familyasından bir çeşit süs bitkisidir. Kullanıldığı yerler: Mide üşütmesinden doğan şikayetleri giderir. İktidarsızlıkta da faydalıdır....
Devamı
Bileşikgiller familyasından; özellikle ılık bölgelerdeki tahıl tarlalarında yetişen bir bitkidir. Çiçekleri mavi veya menekşe rengindedir. Kullanıldığı yerler: İştah açar. İdra...
Devamı